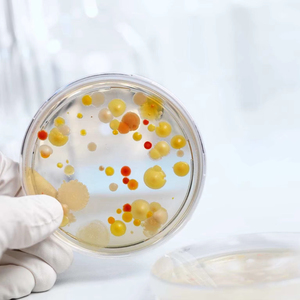
Mesophilic amylase 50.000u/g ~ 100.000u/G đối với đường tinh bột, rượu, sản xuất bia, bột ngọt và kháng sinh - Product Image 5

(Có 5 sản phẩm)

Bất kể loại cây trồng hay cỏ dại nào, Alibaba.com đều cung cấp những sản phẩm thân thiện với môi trường và tiết kiệm chi phí. động mạch chủ toàn thân và các sản phẩm tương tự để đáp ứng nhu cầu riêng của từng nông dân. Kiểm soát cỏ dại với. động mạch chủ toàn thân trong vườn nhà, cây nông nghiệp và chăm sóc bãi cỏ là bắt buộc để giữ cho sản phẩm và bãi cỏ khỏe mạnh và tăng năng suất. Hầu hết các chương trình kiểm soát cỏ dại đều ủng hộ việc sử dụng có trách nhiệm và an toàn các sản phẩm này để không cho cỏ dại có đặc quyền tận dụng ánh sáng mặt trời, chất dinh dưỡng cũng như nước tưới cho cây trồng và bãi cỏ để duy trì sự phát triển chất lượng và sản lượng lớn.
Có sẵn dưới dạng sau phát sinh và tiền xuất hiện ,. động mạch chủ toàn thân có tác dụng ngăn chặn sự tổng hợp protein và axit amin của cỏ dại cản trở sự phát triển và cuối cùng giết chết chúng. Có các tùy chọn không chọn lọc và chọn lọc phù hợp để sử dụng với các loại cây và đất khác nhau. Mua những loại thuốc diệt cỏ dại này ở dạng hạt, dạng lỏng hoặc dạng bột hoàn hảo để xử lý các vấn đề và bệnh thiếu chất dinh dưỡng khác nhau với các đặc tính gây hại của côn trùng khác nhau.
Các. động mạch chủ toàn thân được bán tại Alibaba.com chứa axit chlorophenoxy 2, 4, 5-T và 2, 4-D, hexazione, simazine hoặc atrazine. Một số chất diệt cỏ dại bao gồm clorat, alachlor, dinitroanilines, trifuralin, cyanates, arsenicals, metolachlor, glyphosate, v.v. Chọn từ một loạt các phiên bản cấp chuyên nghiệp, cấp gia đình và cấp thương mại, tất cả đều mạnh mẽ, thân thiện với môi trường và hiệu quả hơn để sử dụng với các loại đất khác nhau.
Tăng cường sự phát triển và sức khỏe của các đồn điền và bãi cỏ với. Các tùy chọn động mạch chủ toàn thân tại Alibaba.com được thiết kế để thân thiện và dễ chịu đối với cây trồng và bãi cỏ. Tìm thuốc diệt cỏ dại chất lượng cao phù hợp với các loài cây trồng và đất khác nhau với tỷ lệ hiệu quả khác nhau. Khám phá các giao dịch và giải pháp phù hợp với loại đất và ngân sách độc đáo.